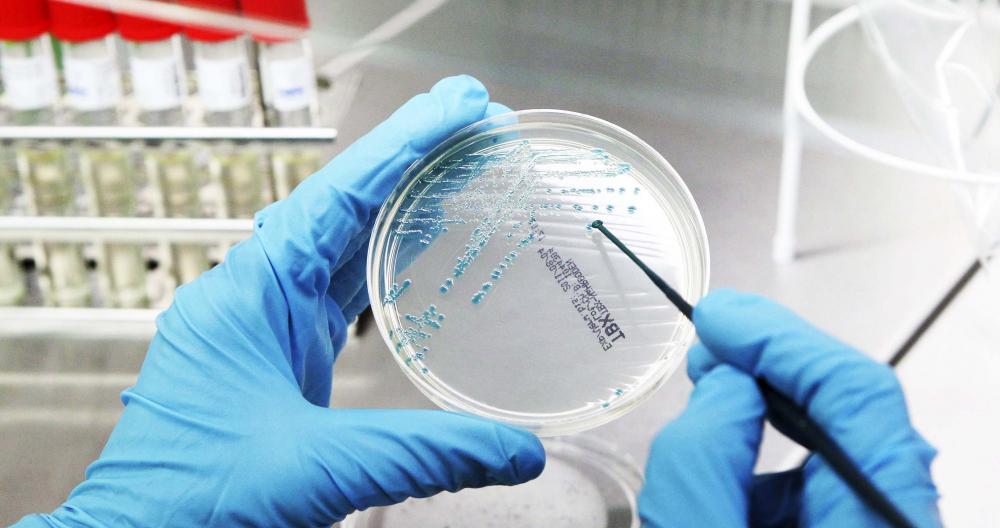

Investigadores y especialistas médicos han detectado más 200 tipos de cáncer que afectan al ser humano, sin embargo, sólo algunos de ellos son considerados como raros porque los padecen una pequeña parte de los pacientes y son poco comunes, lo que los vuelve difíciles de detectar.
Cada 4 de febrero se conmemora el Día Mundial contra el Cáncer, una enfermedad que, de acuerdo con datos de la Organización Mundial de Salud (OMS), es la segunda causa de muerte, ocasionando una de cada seis defunciones a nivel mundial.
El término cáncer sirve para designar un amplio grupo de enfermedades que pueden afectar cualquier parte del organismo cuya característica principal es la multiplicación rápida de células anormales con la capacidad de invadir partes adyacentes del cuerpo e incluso propagarse a otros órganos.
El Instituto Nacional del Cáncer en Estados Unidos indica que un tipo raro de esta enfermedad es aquel que afecta a menos de 40 mil personas por año y representan una cuarta parte del total de muertes a causa de este padecimiento. Se llama cáncer raro, infrecuente o poco común y suelen ser más difíciles de prevenir y de tratar.
Enlistamos cinco tipos de cáncer raro:
- Cáncer de mama masculino
Se forman células malignas en la mama, muchas veces por genes heredados. Es más común en los hombres de 60 a 70 años y representa menos de 1 por ciento de todos los casos de cáncer de mama.
- De seno paranasal
Las células cancerosas se forman en los tejidos de los senos paranasales y la cavidad nasal, es decir, en todos los huecos que rodean la nariz. Es particularmente difícil de detectar porque entre los síntomas está el dolor de cabeza, goteo nasal, sangrado nasal, dolor en los dientes superiores y la hinchazón en los ojos. Después de ser detectado (a través de diversos estudios médicos y pruebas nasales) es necesario detectar dónde se originó la enfermedad.
- Melanoma acral lentiginoso
Es un tipo de cáncer de piel que se presenta en las palmas de las manos o las plantas de los pies. Generalmente las células cancerosas permanecen en la superficie, pero puede diseminarse si no se atiende la afección. Este tipo de enfermedad se presenta con una mancha que no está relacionada con la exposición al sol.
- Meduloblastoma
Se trata de un tumor en el cerebro que se aloja en el cerebelo. Los síntomas más comunes son el dolor de cabeza, vómitos y falta de control muscular. Este cáncer es más común en la niñez, aunque se ha detectado en menor medida en pacientes menores a 50 años. La extraña enfermedad suele ser diagnosticada cuando ya ocurrió metástasis (se extendió a otras partes cercanas).
- Cáncer anal
Se produce debido al crecimiento celular y anormal en la zona del ano. Entre los síntomas están el sangrado rectal, dolor, comezón y aparición de bultos en el área.
De acuerdo con la Biblioteca Nacional de Medicina de Estados Unidos, este tipo de enfermedad se propaga lentamente y puede ser fácilmente tratado si se detecta a tiempo.
El Instituto Nacional del Cáncer señala que al ser un padecimiento extraño, todo tipo de cáncer infantil es considerado raro.
El Departamento de Investigación del Instituto antes mencionado indica que este tipo de cáncer es un desafío para pacientes, médicos y científicos porque puede transcurrir mucho tiempo antes de detectarlo y muchas veces se desconoce el tratamiento
La OMS advierte que hay principales factores conductuales y dietéticos que aumentan el riesgo de padecer cáncer: tener un índice de masa corporal elevado, consumo reducido de frutas y verduras, falta de actividad física, consumo de tabaco y consumo de alcohol.
La Organización promueve cada 4 de febrero jornadas de acción para que los gobiernos y la sociedad implementen medidas de prevención y tratamiento, pero principalmente para concientizar sobre los alcances de este padecimiento a nivel mundial.
Fuentes: Organización Mundial de la Salud / Worldcancerday.org / Instituto Nacional del Cáncer en Estados Unidos (National Cancer Research) / Centro de Información Genética y Enfermedades Raras (Genetic and Rare Diseases Information Center)
Edición: Mirna Abreu
'La naranja mecánica' aplasta 5-1 a Suecia; se mete en la pelea por liderato de su conjunto
Afp
Aplicaría al término del alto el fuego de 60 días previsto
Afp
La unidad pesada se quedó sin frenos e impactó a varios vehículos
La Jornada
El hallazgo fue posible gracias a la colaboración de ejidatarios, voluntarios y fuerzas de seguridad
La Jornada Maya